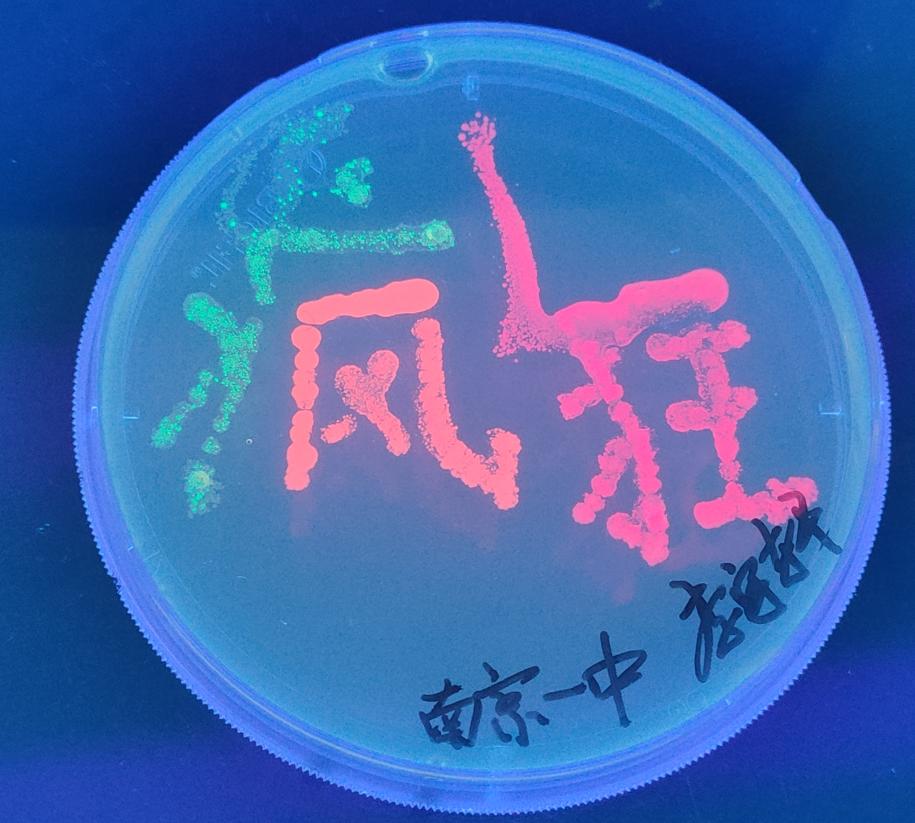

天才预备役“丘成桐少年班”,能否重新定义人才培养模式?
原创 庄晓 外滩教育
看点
拔尖人才的培养,一直是教育界关注的重点。随着“丘成桐少年班”在全国18所学校挂牌亮相,有关“拔尖人才”的培养实践,也被推至大众视野。那么作为未来学科拔尖人才的“预备役”,“丘成桐少年班”的筹建,和以往的“天才班”有什么异同?顶级中学又是如何“慧眼识英才”,挖掘并培养这些优秀的“天才”们呢?
文丨庄晓 编丨Lulu
一边心不在焉地刷着手机,一边不时向考场张望的陈蓉,直接将焦灼写在了脸上。在她身旁同样站着不少家长,或是低声交流、或是安安静静地守在一旁。
某种程度来说,他们都是被人羡慕的对象。因为孩子足够优秀,他们得以见证着今年“丘成桐少年班”(下文简称“丘班”)的选拔。
在陈蓉眼中,这场考试本身就自带光环,最引人关注的亮点,自然落到了著名数学家、教育家丘成桐先生的身上。
作为中国数学教育的观察者、批评者和建设者,丘成桐始终致力于中国拔尖人才的培养。
为提升中学生对数学研究的兴趣,2008年,丘成桐设立“丘成桐中学数学奖”(“丘奖”,后发展为“丘成桐中学科学奖”)。不同于一般竞赛,参赛者可自行选择感兴趣的题目,以提交研究报告的形式参赛,让中学生也能体会一把做科研的滋味。
2010年,他又发起“丘成桐大学生数学竞赛”(“丘赛”),全面考察参赛大学生的数学基础知识和技能,希望能提升中国大学生的数学基本功。
同时,他还发起了世界华人数学家大会(ICCM),创办有“华人菲尔兹奖”之称、颁给45岁以下青年学者的ICCM数学奖,为加强海内外华人数学家的联系,发挥了重要的作用。
甚至,为了鼓励更多女生投入数学学习,2021年,他还发起了“丘成桐女子中学生数学竞赛”。
上下滑动阅读更多内容
然而,一系列的努力下,丘成桐依然还有一道困扰多年的难题,亟待解决。这道题的题目就是:如何在中国培养出世界顶尖的大数学家。
纵观当下学生的培养路径,丘成桐认为,对于特别有才华的学生而言,以中考和高考为目标的训练,实在有些过于浪费时间,有望成为未来数学家的他们,理应有更好的选择。
为此,丘成桐将优秀人才的教育革新,延伸到了中学阶段。
2020年底,清华大学推出了“丘成桐数学科学领军人才培养计划”,每年遴选100个左右具有“突出数学潜质和特长,并有志于终身从事科学研究”的高中生和特别优秀的初三学生,无须高考,入学后直接接受为期八年的本硕博衔接培养。
2021年,全国15个省市的优质18所中学纷纷成立了“丘成桐少年班”,采取初高中贯通、大中学联动方式培养,进一步探索数学等基础学科人才的早期培养,为国家输送数学学科拔尖创新后备人才。
可以说,从丘奖、丘赛到如今的丘班,丘成桐一直在尝试打破现有框架的桎梏,希望能探索一条更有效的“拔尖人才”培养路径。
不过,对于考场外已经等待了近四个小时的陈蓉来说,她更想知道,“丘成桐少年班”和以往的“天才班”有何不同?
“丘班”是如何挑选颇具潜力的孩子?这条有别于传统升学路径的人才培养模式,又是怎样培养这些“拔尖”的学生呢?
 “拔尖人才”的诞生
“拔尖人才”的诞生第一次站上“丘班”的讲台上时,殷俊的心情并没有太多的起伏。作为南京市第一中学(以下简称“南京一中”)专门指导生物竞赛的老师,他曾在自己的执教生涯中,见过太多天才的学生们。经验丰富的他,也成为了南京一中首届“丘班”的班主任。
2022年4月,南京一中成为全国首批开创“丘班”,率先在探索“拔尖人才”培养上,就教育资源的协同、课程教学的改革以及教学评价等方面都做出了创新和尝试。在“丘班”筹备之初,南京一中就请来了东南大学等高校教师,对后续课程体系进行了全面梳理。
 南京一中校园一角
南京一中校园一角殷俊告诉外滩君,当时,南京一中首批“丘班”的招生对象,以南京市2022年应届初三毕业生为主。
和以往纯搞竞赛的“理科班”不同,“丘班”一早就提出了“构建高学术性、高融合性、高活动性”的课程体系,不设淘汰制,学生可以自行选择加入还是退出竞赛学科的学习。
 南京一中首届“丘班”的班主任殷俊
南京一中首届“丘班”的班主任殷俊眼看“拔尖”人才培养的号角已然奏响,挑战也随之而来。
彼时,大家对于“丘班”的理解,还停留在要培养出未来领军数学家的蓝图中。如何才能挑选出未来颇具潜力的孩子,却没有太多现成可供参考的模式。
“当初选拔时,我们就考数学和物理这两门”,但经过一段时间的学习后,殷俊发现,“一些孩子偏科比较严重,语文和英语不太好,导致学业考试总分并不占优。”
南京一中的“丘班”孩子,还要兼顾参加统一的年级考试。个别科目跟不上进度的学生,在期中或期末考试中暴露了过于偏科的短板,不利于他们今后在基础学科领域更加深入地学习。
育人方式的变革,创新人才的培养,一直在探索中。到底什么样的孩子,才能称得上是“拔尖人才”?
 在清华大学求真书院的官网上,丘成桐先生给出了回应。他认为,如果说求真书院要培养的是“有能力、有远见的通才,真正耐得苦,对学问真正有兴趣”,那么中学教育中,奥赛不是数学教育的重点,要培养的也绝不仅是竞赛人才。
在清华大学求真书院的官网上,丘成桐先生给出了回应。他认为,如果说求真书院要培养的是“有能力、有远见的通才,真正耐得苦,对学问真正有兴趣”,那么中学教育中,奥赛不是数学教育的重点,要培养的也绝不仅是竞赛人才。真正要培养的则是“有能力、有抱负,懂数学、懂科学,有文化、有内涵的通才”。
因而,第二年“丘班”的招生选拔,南京一中就吸取了首届招生的经验,不仅仅考数学、物理,而是全面考察学生数学、语文、外语、物理和化学等五门学科,同时还增加了数学的加试。
考试范围以初中学科为主,知识的深度和广度,还是有所拔高。殷俊解释,“主要还为了考察孩子的学习能力。”
当然,“拔尖”人才的选拔过程,也有不同的声音在讨论。对于还在成长发育期的中学生而言,仅凭一张试卷,真就能筛选出一批最优秀的大脑吗?
南京市第十届物理学科带头人、第二届南京一中“丘班”的班主任刘宗涛,对此也诚恳解释:“作为一种选拔考试,考生的应试能力当然非常重要,但挖掘学生的潜能也是同等重要。”
 南京市第十届物理学科带头人、
南京市第十届物理学科带头人、第二届南京一中“丘班”的班主任刘宗涛
除了初试环节外,南京一中还会邀请学生和家长,展开面对面的沟通。
“面谈中,我们会看学生整体的气质,还看他们良好的表达能力和积极的进取心态。”刘宗涛介绍,即便是顺利通过了最初的笔试,每年也还会有个别学生谨慎考虑“丘班”的选择。
他们的理由是不想进入“一种过度被卷的状态”,因为进入“丘班”,必然需要学生在兴趣爱好的课程上,投入更多的时间,迎接更多的挑战。
因此,除了足够的脑力、心力外,“丘班”的老师们更希望能在选拔中,看到孩子们的热情和毅力。
近些年来,设在南京一中的“江苏少工院”,还专门面向南京全市六七年级的孩子,增设各类公益的兴趣讲座、举办冬令营和夏令营。
作为参与活动的带队老师,殷俊和刘宗涛都会在各种活动中,观察这些孩子们面对挑战的心态,以及他们对于未知学科的兴趣。
多方的考察和多轮谈话后,“丘班”的名单才最终尘埃落定。漫长的组班过程,既有“丘班”的求贤若渴一面,也有双方更为谨慎的选择。
 南京一中校园一角
南京一中校园一角面对今后“丘班”是否又会是一场“鸡娃”军备赛的争议,殷俊反倒觉得不用太过担心。
”一来,每年学校“丘班”的选拔试卷是严格规范保密的。作为离“丘班”最近的人,他们并不知道有关试卷的丝毫细节。
二来,“丘班”遴选的方式变得更加多元。“丘班选拔不是一种纯粹的应试,当然它会以考试的形式出现,不过我们希望在这个基础上,让整个选拔过程变得更加灵活。”殷俊说。
 入选“丘成桐少年班”
入选“丘成桐少年班”俗话说,好看的皮囊千篇一律,有趣的灵魂万里挑一。外滩君也不由好奇,历经层层选拔,那些打上“丘班”印记的少年们,都有怎样独特的灵魂?
作为未来的数学家们,他们身上又带有哪些特质?是否还会像我们刻板印象中的竞赛生那样,“两耳不闻窗外事,一心只读竞赛书”?
和“丘班”学生朝夕相处两年后,殷俊给这些新一代的“天之骄子”们,画出了一幅速写。
 南京一中高二“丘班”师生
南京一中高二“丘班”师生首先,他们身上既有旺盛的求知欲,同时还有着让人放心的沉稳。
在去年世界华人数学家大会的欢迎晚宴上,南京一中首届“丘班”的班长包佳昊,当着全场重量级嘉宾面,畅谈了首次参加数学盛宴的感悟。
从通知要即兴发言,到正式上台致谢,包佳昊只有短短几分钟的准备时间,不过殷俊还是欣慰地看到,自己的得意门生不仅落落大方地完成了任务,其余受邀参加的“丘班”全体学生们,也似初出牛犊不怕虎,积极和这些世界重量级的数学家们,展开了互动和交流。
“他们都有着旺盛的好奇心、求知欲和上进心,还有一种随机应变的能力,一种勇气,以及积极行动的品质。”
其次有着极强的思维能力,善于深度思考。
比如在已经玩出花样的《红楼梦》选段编排中,首届“丘班”的孩子,就给全校师生带来了一次耳目一新的表演。他们不仅自己搞定了服化道,还创新性地改编了《红楼梦》剧本,以曹雪芹和跛足道人两人的对话方式,回顾并评价了宝玉出家前所经历的一次次人生大事。
 “丘班”《红楼梦》剧本表演
“丘班”《红楼梦》剧本表演无论是表演的流畅度,还是思考的深度和广度,“丘班”这出有关《红楼梦》的改编剧目,都获得了全校语文教学组的一致好评。
和“丘班”学生相处近半年的刘宗涛,也感受到这群学生如火一般的热情。“几乎所有任课老师共同的感受都是,丘班学生的思维特别活跃,发言也非常积极,甚至在课堂上都会出现争执和讨论。”
同时,这些孩子们也有着强大的执行力和团队合作的能力。
在今年新一届的“丘班”开学军训上,孩子们需要表演《少年中国说》的合唱节目,而可供全班准备的时间,却只有一天。
一番讨论后,全班49位同学仅用了15分钟,就自发分配好哪些同学做群众演员、哪些上台表演军体拳、哪些担任合唱和主唱、哪位负责做总指挥。
最终,整场表演既有军体拳演示背景、又有一个指挥、四个主唱、多位合唱等多种艺术表现形式,在舞台上呈现了不错的效果,也留给了刘宗涛深刻的印象。
 “丘班”学生军训中
“丘班”学生军训中最后,还有一个让人不知“是好是坏”的特质。
那就是相对于文史哲这类课程,“丘班”学生们还是更偏爱理性思维的探讨。在需要背诵的文科学习中,他们多少有些提不起兴趣。
但刘宗涛觉得,真正高效、深入的思维模式,都是文中含理,理中含文,“记忆背诵、语言的表达和组织,本身也会给逻辑思维带来一定的影响。”不论是学贯中西的丘成桐、还是文理、科艺兼顾的杨振宁,都为“丘班”的学生,提供了榜样力量。
他认为,当一个孩子特别聪明的时候,教育者也应该特别注意孩子人文气息的培养。
“孩子的聪明和智力,可以让他走得快,但是一些情感得体的表达,及一定的节制,这些东西可以让他走得更远。”作为他们的老师,刘宗涛更希望“每个孩子都能奋力发挥自己的才情,过上幸福自如的求学生活。”
 南京一中高一“丘班”学生
南京一中高一“丘班”学生 “英才”的预备役
“英才”的预备役“丘班”的学生,并非“五项全能”。虽然早有一些高中学科知识的铺垫,但面对高中全新的知识体系,他们同样需要时间来适应和调整。
不过,他们总有办法大幅缩小适应的时间。首届“丘班”开班没过多久,殷俊就发现,准备了整整一堂课的内容,有时仅用了半节课就能全部讲完。若是相应提高授课难度,这些天生就“大胃口”的孩子们,反而在课堂上变得更加活跃。
因此,如何让这些不畏挑战的孩子,既能吃得饱、也要吃得好,就成了刘宗涛在备课中,经常要思考的问题。
题目不能太难,又不能太简单。“如果一味去选取竞赛习题,既不利于他们今后的全面发展,也违背了我们的初衷”,所以在备课之余,刘宗涛会把大量的时间花在资料的编选中,寻找那些“高于高考、但同时能给他们思维带来挑战的题目。”
 在这些天才少年面前,传统课堂教授方式,已无法满足他们对于知识的渴求。为此,刘宗涛将“席明纳教学法”,引入了“丘班”日常的课堂。
在这些天才少年面前,传统课堂教授方式,已无法满足他们对于知识的渴求。为此,刘宗涛将“席明纳教学法”,引入了“丘班”日常的课堂。这个起源于德国大学教学中的方法,多指在教授指导下,优秀学生定期组成小组探索新知领域。通常,刘宗涛会在课上抛出一个主题式的问题,让孩子们上台演讲、相互讨论和质疑。
一次有关“受力分析”的“习明纳教学法”中,刘宗涛会先向学生们介绍整体法和隔离法的处理方式,让孩子们自行思考、独自消化吸收;
接着,他会请四位同学分别从代数、几何、逆向运算等多个角度,对这一问题进行阐述。
台下的同学也能就台上同学的讲述,对比各自想法的优劣之处,最终选择一个适合自己的理解及运算方式。
刘宗涛认为,“这些思维的碰撞,能让每一个学生都有效参与课堂,同时还能提供一题多解的不同视角。”
往往越是辩论,孩子们越能理解“每个东西的存在,都具有一定的合理性和局限性,就像盲人摸象一样,每个学生都能在讨论中触摸到真理的一部分,但只有当所有人把这些线索拼凑在一起时,才能得出一个整体而全面的印象。”
以往,刘宗涛也会试着在普通班级里,采用席明纳的教学方法,可整体教学效果却不尽如人意。
但在“丘班”,学生们对这样的教学方法充满了热情,类似的头脑风暴几乎随时都有可能在课堂发生。刘宗涛把这样的课堂生成,命名为“即兴席明纳”,只要遇到可供讨论的问题,他就随时会让孩子们展开思维火花的碰撞。
 为了兼顾班上同学的竞赛学习,“丘班”采取了前期加快教学速度,竞赛季放缓的教学节奏。这无疑也对学生自我学习和管理提出了更高的要求。
为了兼顾班上同学的竞赛学习,“丘班”采取了前期加快教学速度,竞赛季放缓的教学节奏。这无疑也对学生自我学习和管理提出了更高的要求。为此,殷俊会特意在日常的教学中,加入限时训练的方法。每次40分钟的晚自习上,他一般会安排50分钟的习题量,要求学生限时完成。
在家庭作业的布置中,殷俊反而显得有些“佛系”。在他看来,越是成绩好的孩子,越需要自主学习整理的时间。常会关注学生作业量的殷俊告诉外滩君,“目前,丘班家庭作业基本上8点之前,大家都能顺利完成。”
 不得不说,丘班的学生们,确实天资聪颖,不过若是从班级管理角度来看,要管理全班四十多位智力超群的学生,恐怕又是另一番不那么美妙的滋味了。
不得不说,丘班的学生们,确实天资聪颖,不过若是从班级管理角度来看,要管理全班四十多位智力超群的学生,恐怕又是另一番不那么美妙的滋味了。开学伊始,单是就“轮换座位”的小事,刘宗涛就和学生们,商议出了一个复杂的办法。
“比如我们的座位,当时有前三排轮换、前后轮换、或者左右轮换等比较复杂的换法。”集体生活两三个月后,刘宗涛又在班上,就轮换座位这件事,启动了新的机制。
“你可以提出不建议和谁坐一起的理由,但是你不能说我要和谁坐一起。”刘宗涛希望,这些从小就被寄予厚望的孩子们,能从换座位的小事出发,学着去接纳别人的不同。
在“丘班”,哪怕是再忽略不计的小事,也都力争设计成人人参与的“大事”,孩子们的点滴改变,也在慢慢发生。
有次,一位学生就“己所不欲勿施于人”,私下和刘宗涛进行了探讨。他觉得这句名言后面,还能再接上一句“己所甚欲勿施于人”。
刚开始,刘宗涛还不太能理解学生的意思。但孩子随后解释,如果有一件特别想做、特别热衷的事情,你也要学会克制,不要把它强加到别人的身上。
这句话听完,刘宗涛触动很大。虽然这位学生的本意,是指在解题过程中,把自己的想法强加于人,别人也未必能接受,但这也从侧面说明,孩子们正慢慢学会接纳和包容彼此、心智上也正慢慢变得成熟。
 “丘班”学生参与青春诗会的活动
“丘班”学生参与青春诗会的活动“都说教学相长,我也很荣幸能成为这场拔尖人才培养改革的旁观者;他们成长的忠实记录者;以及智慧追求的同行者,和他们一起成长。”刘宗涛感叹道。
 小结
小结通才的培养离不开社会资源的协同帮扶。在保证了足量高效的课堂教学外,南京一中又联合了南京大学、东南大学、南京航空航天大学、科研院所等,为“丘班”提供院士1课堂(3年打造100节院士课堂资源)、竞赛课程、科技实践课程、大学先修课等特色课程。
 东南大学老师给“丘班”学生授课
东南大学老师给“丘班”学生授课在大学先修系列课程上,高一的“丘班”学生就能选修微积分、线性代数和大学物理等课程,任教老师则来自东南大学丘成桐中心。学期实践课上,他们还参观了清华大学饶子和院士的实验室、丘成桐先生的求真书院以及贵州中国天眼。
今年暑假,他们还在苏州冷泉港,亲手实操了基因工程实验,培养荧光蛋白细菌,学着用细菌作画。一顿操作后,有的人画出了图案、有的人却没有结果。这次亲身经历,也生动教会了这群少年们,严谨在未来科研中,到底有多重要。
“丘班”孩子的细菌作画
“丘班”孩子的细菌作画今后的假期,殷俊打算带孩子们去看国家大数据中心,游目骋怀之余,让孩子们感受现代科技正发生着日新月异的变化。
不久前,在南京一中举办的第五届高中学历案研究论坛上,校长朱焱总结拔尖人才的创造“需要更高层面、更大范围的整体设计和谋划,需要更加细致、更为严谨的科学研究的支撑和指导,需要更多打破常规、打开局面的创新实践。”
过去数年,在教育界有关“公平普惠”和“英才培育”的纷争中,拔尖人才的培养举步维艰。天生就有“好胃口”的孩子们,或是在竞争更加激烈的竞赛路线上一路打怪升级,或是沉于书山卷海、重复早已熟稔的练习。
现在,作为创新人才培养探索的前沿,“丘班”无疑给了他们全新的路线,让他们自由充分地找到兴趣,在屡败屡战的挑战中,也能保持热诚如初。给每个有差异的孩子,提供能力相当的教育,也是一种更高水平的教育公平。
在接受新华社采访时,丘成桐曾说,“希望十年后,能够看到在中国本土成长的第一个菲尔兹奖得主。”相信这样的等待,也将不会太久,而萦绕在我们心头的“钱学森之问”,也将终能找到答案。
全国18个“丘成桐少年班”名单:
中国人民大学附属中学、清华大学附属中学、深圳中学、西北工业大学附属中学、华东师范大学附第二属中学、重庆市巴蜀中学校、东北师范大学附属中学、吉林大学附属中学成都市第七中学、杭州学军中学、南京外国语学校、南京市第一中学、华南师范大学附属中学、雅礼中学、贵阳市第一中学、山东省青岛第二中学、浙江乐清市知临中学、北京师范大学附属实验中学
参考:《解题者丘成桐》新华每日电讯。
文章图片均由南京市第一中学提供。
原标题:《天才预备役的“丘成桐少年班”,能否重新定义“拔尖”人才的培养模式?》

